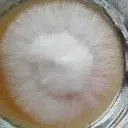
Cepa de Pleurotus

Cepa de Pleurotus
Las diferentes variedades de Pleurotus cultivadas por "Fungiterra" son altamente competitivas en el mercado, dado que son empleadas de manera constante a lo largo de todo el año y en una escala de producción considerable. Estas cepas se resguardan en un banco de cepas altamente especializado, lo que asegura de forma absoluta su calidad e inocuidad para su uso en diversas aplicaciones. (NOTA: Nunca te venderemos variedades sin probar).
$ 2.000,00
$ 2.000,00
IVA incluido
$ 2.000,00
IVA incluido